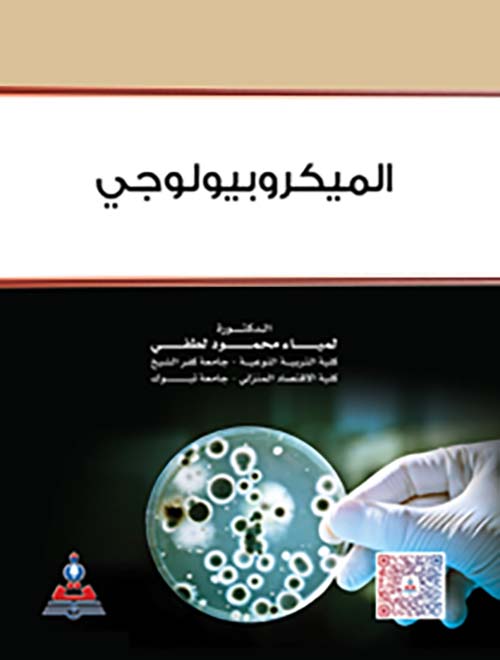

الميكروبيولوجي
الكاتب: لمياء محمود لطفي
تصنيف: العلوم و الطبيعة / بيولوجيا
الناشر: دار الثقافة للنشر والتوزيع
السّنة: 2016-01-01
ردمك: 9789957169266
السّعر (USD): 6.0
نبذة: لدراسة علم الميكروبيولوجي الذي يُعنى بدراسة الكائنات الحية الدقيقة والنشاط الذي تقوم به، لا بد لنا من منهجية تقوم على تقسيم هذا الكتاب إلى جزأين، يتناول الأول منه القسم النظري من الموضوع، بحيث يتطرق إلى علم الأحياء الدقيقة وتقسيمها، مع التوقف عند البكتريا والشكل الظاهري لها، ومن ثم الحديث عن